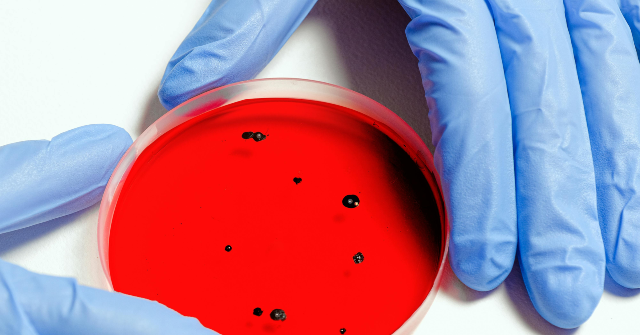
Health Officials in NYC Caution About Legionnaire's Disease Outbreak

Local leaders announce that the peak of the Legionnaires’ disease outbreak has passed, though 24 individuals are still in the hospital.

Officials in New York City indicated on Thursday that the worst of a significant outbreak of illness, which resulted in three fatalities and affected several dozen individuals, is likely over. Health officials reported that five postal codes were impacted, leading to at least 24 hospitalizations nearly two weeks after the initial detection of pneumonia-like illnesses […]
Legionnaires’ outbreak expands: What are the initial symptoms of the disease?

Three individuals have lost their lives, and at least 67 have been infected as an outbreak of Legionnaires’ disease in New York City expands. The rise in cases is connected to a bacteria outbreak that began making people ill in late July. Health officials in the city believe that a central cooling tower, which is […]
Third fatality in Harlem Legionnaires’ outbreak that has affected nearly 70 people

On Wednesday, Mayor Adams announced that a third individual has died due to an outbreak of Legionnaires’ disease in Harlem. This alarming cluster, which includes cases of severe lung inflammation, was first identified on July 25. It has impacted five postal codes in upper Manhattan, affecting at least 67 people. The identities of the three […]
Legionnaires’ disease outbreak affects many with bacterial pneumonia in a large city

Health authorities have reported that a bacterial pneumonia outbreak has affected many people in New York City. Specifically, 58 individuals have been diagnosed with Legionnaire’s disease, which is caused by the Legionella bacteria. The NYC Health Department confirmed, in a news release on August 4, that there have been two fatalities associated with this outbreak. […]
Two people have died as Legionnaire’s cases in NYC rise to 58.

A recent outbreak of Legionnaires’ disease in Harlem has resulted in the deaths of two individuals, with 58 more reported cases. It’s quite alarming that the case count has doubled in just a few days, as noted in an update on Monday. The New York City Department of Health (DOH) has identified clusters of pneumonia […]
Legionnaires’ disease outbreak in Harlem results in one death and 22 illnesses as health officials express concern

A New Yorker has died, and at least 22 others are ill due to a Legionnaires’ disease outbreak in Harlem, according to local health officials. This news comes as a bit of a shock for the community. The New York City Health Department reported on Wednesday that clusters of pneumonia-like illnesses were first noticed on […]
Health Officials in NYC Caution About Legionnaire’s Disease Outbreak
Health Officials Warn of Legionnaires’ Disease Outbreak in NYC New York City health officials are alerting residents about an outbreak of lung infections linked to specific zip codes. As reported by ABC 7, the disease in question is Legionnaires’ disease, with several cases documented recently. In an update from the New York City Health Bureau, […]
Massachusetts woman Barbara Kruschwitz dies from Legionnaires’ disease after stay at NH resort with contaminated hot tub

A Massachusetts mother of three and former physical therapist died from Legionnaires' disease after staying at a luxury resort in New Hampshire, and another guest was hospitalized with the infection months later. New Hampshire health officials say two guests who had booked a stay at the Mountain View Grand Resort & Spa tested positive for […]









